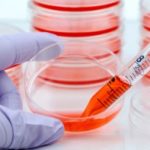

March is Save Your Vision Month 2016, which sheds light on diseases and conditions that can affect vision, including glaucoma and other vision disorders, along with Down syndrome and how this genetic condition can affect your vision as well.
Vision can deteriorate with aging, but you don’t have to lose it completely just because you are getting old. By reading up on some of these articles, you can learn more about vision disorders, tips to improve your vision, and basic methods to save your vision overall .
Common medication that can help improve your vision
Advertisement
New research has found that common statins may help restore vision in patients with age-related macular degeneration (AMD), the most common and leading eye problem, which contributes to blindness.
The findings come from researchers at Massachusetts Eye and Ear/Harvard Medical School and the University of Crete who have already completed clinical trials in the investigation of statins as a means to restore vision.
The researchers found treating AMD with atorvastatin (80mg) was not only associated with a drop in LDL cholesterol, but patients also experienced improvements in vision. The findings further evidence that cholesterol and vision problems share a relationship, and reveal a possible new form of treatment for both conditions.
Age-related macular degeneration is a common eye and vision problem that comes with age. Anyone can develop age-related macular degeneration, but it doesn’t necessarily have to become a normal part of aging. AMD is the leading cause of blindness worldwide and commonly affects seniors over the age of 60. Seniors should be regularly undergoing eye exams in order to monitor their vision and make necessary adjustments to their lifestyle as well, including wearing prescription glasses.
Lead researcher Joan W. Miller noted that statins have the potential to remove lipid debris, which could be responsible for vision problems in patients with age-related macular degeneration.
The researchers are hopeful that their findings will go on to help the millions of patients who are affected by AMD. Continue reading…
For vision disorders in Down syndrome patients, researchers investigate new strategies
Vision disorders in Down syndrome patients prompted researchers to investigate new strategies in order to improve sight. Researchers from the University of Houston’s College of Optometry have found a new computer-simulated prescribing strategy for glasses which can improve vision in Down syndrome patients.
Over 400,000 Americans have Down syndrome, which is a genetic disorder leading to poor muscle tone, intellectual disability, and visual defects. Oftentimes, Down syndrome patients require strong eye glasses prescriptions, and misalignment of the eyes can reduce vision even with corrective lenses.
Principal investigator Heather Anderson said, “The motivation for our study is a recent finding that individuals with Down syndrome have increased levels of distortions in the optics of their eyes that we believe leads to poorer visual acuity with current spectacle prescribing methods than the typical patient eye with fewer distortions. We hope to demonstrate improved acuity with prescribing strategies that are derived when considering these higher level optical distortions.” Continue reading…
Green leafy vegetables help reduce the risk of glaucoma
A new study suggests that consuming green leafy vegetables regularly can reduce the risk of glaucoma by 20 percent. Study leader Jae Kang said, “We found those consuming the most green leafy vegetables had a 20 to 30 percent lower risk of glaucoma.”
When fluid increases within parts of the eye this causes pressure which in turn damages the optic nerve thus contributing to vision loss.
Kang and his team followed 64,000 participants between 1984 and 2012 and another 41,000 participants between 1986 and 2014. None of the participants had glaucoma at the beginning of the study.
After a 25 year follow-up, 1,500 participants developed glaucoma. Researchers then analyzed consumption of green leafy vegetables among the participants. Participants were divided into five groups based on their green leafy vegetable consumption. In the higher consumption groups participants averaged 1.5 servings a day and the lowest was one serving every three days. Continue reading…
Transplanted placental stem cells can help improve vision
Stem cells have been in the spotlight for some years now, but of late they have been on the cutting edge of science and are heralding a new era in health technology. The latest addition to the stem cell research juggernaut is a study in South Korea where a team of researchers took mesenchymal stromal cells (MSCs) from the amniotic membranes of human placenta (AMSCs) and successfully transplanted them into laboratory mice. The mice were pre-modeled with retinopathy.
Basically, through the study, they were hoping to squash abnormal blood vessel growth that often causes different eye diseases, like diabetic retinopathy and age-related macular degeneration. During the study, the team of researchers observed that the amniotic stem cells traveled effortlessly to the retinas of the mice and were able to stop the abnormal growth, thanks to the growth factors secreted by the cells.
The details of the study are currently available on-line and will soon be published in Cell Transplantation.
MSCs have three distinct advantages in stem cell treatment.
One, as they are multipotent, they can easily self-renew and differentiate into a variety of specialized cell types, such as chondrocytes (cartilage cells), myocardiocytes (heart muscle cells), osteoblasts (cells that contribute to bone formation), adipocytes (fat cells), and neuron-like cells (nervous system cells). Continue reading…
Failing vision linked with shorter life in seniors
The findings were concluded based on research conducted on more than 2,500 senior adults – aged 65 to 84. Their vision was assessed at the beginning of the study and once again two, six and eight years later. Researchers found that vision loss was associated with the shortening of the seniors’ lives.
It may appear obvious that the worse vision gets, the less years you may have, but researchers do offer some theories which may better link poor vision and a shorter life.
Researchers suggest that when seniors lose their vision, they also lose their ability to perform simple daily tasks. From their findings, researchers pointed out death associated with the inability to perform daily tasks increased three percent each year of the study – after eight years risk of death was up to 31 percent.
Advertisement
Participants whose eye exams revealed their vision declined a letter size on the eye exam chart had a 16 percent increased risk of death due to the inability to perform daily tasks.
The research team said, “Our findings have multiple implications. First, these findings reinforce the need for the primary prevention of visual impairment. Moreover, the early detection of disabling eye diseases is suboptimal in the U.S. health care system, leading to otherwise preventable vision impairment. Finally, many Americans live with vision impairment that is correctable through the proper fitting of glasses or contact lenses.”
Lastly, the findings suggest that with failing vision, seniors require further assistance in order to reduce their risk of death by inability to perform daily tasks. Continue reading…